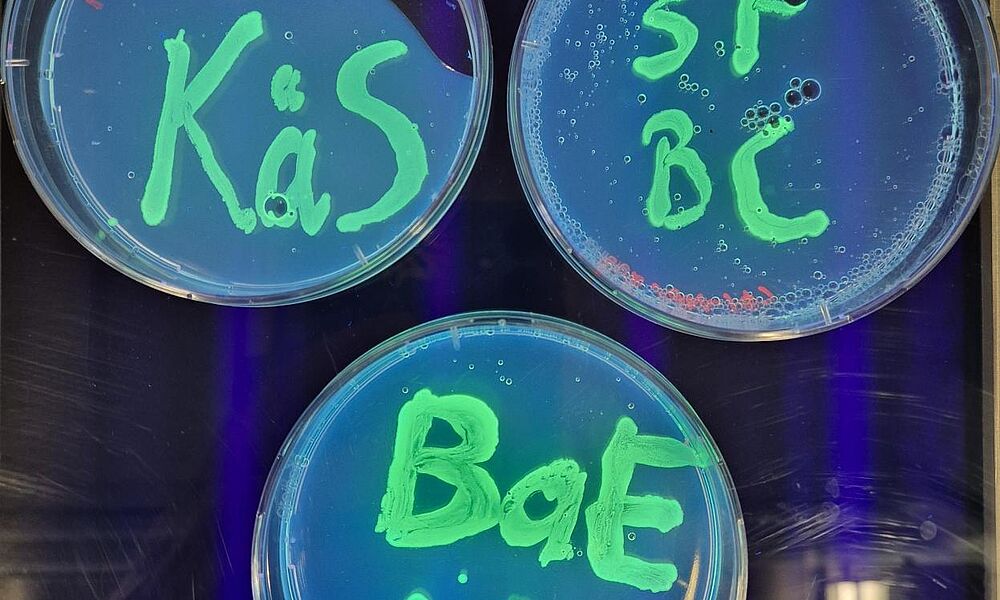

Gymnasium
Biotechnologie zum Anfassen
Eine Woche voller faszinierender Experimente und wissenschaftlicher Präzision: Während der Schwerpunktfachwoche tauchten Lernende des Jahrgangs GYM1 des Schwerpunktfachs Biologie/Chemie in die Welt der Mikrobiologie und Gentechnik ein. Anspruchsvolle Laborversuche ermöglichten ihnen, modernste biotechnologische Methoden kennenzulernen und praktisch anzuwenden.
Von der präzisen Erzeugung gentechnisch veränderter Bakterien über DNA-Analysen bis hin zur Aufklärung eines fiktiven Verbrechens – die Lernenden erlebten hautnah, wie vielseitig und zukunftsweisend die Biotechnologie ist. Neben den technischen Fertigkeiten stand auch die Kollaboration und Zusammenarbeit im Fokus: minutiöse Absprache, Teamarbeit und gemeinsames Problemlösen waren gefragt.
Die SF-Woche ist jedoch mehr als nur Laborarbeit – als krönender Abschluss des Schwerpunktfachunterrichts fordert und fördert sie die Schülerinnen und Schüler und bereitet sie optimal auf die bevorstehenden Maturaprüfungen vor.
Eine inspirierende Woche, die nicht nur Wissen vermittelt, sondern auch den Forschergeist weckt!
Innovationsworkshop zur Weiterentwicklung der Maturitätsschulen
Vom 30. Oktober bis zum 1. November 2024 fand auf Schloss Thun ein intensiver Innovationsworkshop mit einem 15-köpfigen, abteilungsübergreifenden Team (Volksschule, FMS und Gymnasium) der NMS Bern statt. In inspirierender Umgebung und mit professioneller Moderation durch eine externe Fachperson arbeiteten Lehrpersonen der verschiedenen Abteilungen während 2,5 Tagen mit Methoden des Design Thinking an der Zukunft der beiden Maturitätsschulen der NMS.
Der erste Schritt des 2,5-tägigen Innovationsworkshops bestand darin, sich der sich abzeichnenden Trends und Veränderungen im gesellschaftlichen, technologischen, ökonomischen, ökologischen, politischen und professionellen Umfeld der NMS Bern bewusst zu werden. Diese Analyse bildete die Grundlage, um die Schul- und Unterrichtsentwicklung gezielt auf zukünftige Herausforderungen auszurichten. Im Anschluss daran entwickelten die Teilnehmenden erste Ideen, wie Lernen und Lehren an der NMS im Sinne einer zukunftsfähigen Bildung neu gedacht und gestaltet werden kann.
Ein zentrales Ergebnis dieses Workshops war der Entwurf eines neuen, schülerzentrierten Unterrichtskonzepts, das ab dem Schuljahr 2025/26 auf den Stufen GYM1 und FMS3 umgesetzt wird. Im Fokus steht das eigenverantwortliche, begleitete Lernen in sogenannten individualisierenden Lerneinheiten. Diese umfassen alle nötigen Materialien, Informationen und Aufgaben und ermöglichen den Lernenden drei Lernwege: die Teilnahme an Lehrinputs, das begleitete Lernen im neuen Co-Learning Space sowie das selbstständige Arbeiten ohne direkte Begleitung. Die Lernenden werden dabei gezielt unterstützt, um ihre Selbstständigkeit und Eigenverantwortung schrittweise zu stärken.
Mit dem Co-Learning Space wird ein Lernort geschaffen, der auf den erfolgreichen Erfahrungen der Volksschule der NMS aufbaut: Ein individuell gestaltbarer Arbeitsplatz steht den Lernenden während des Schuljahres zur Verfügung. Inputs und Reflexionsphasen finden in separaten Räumen statt, während die Lehrpersonen als Lernbegleiter*innen agieren – beratend, unterstützend und motivierend.
Gleichzeitig wurde die Zusammenarbeit über die Abteilungen hinweg gestärkt. Die Fachschaften entwickeln die individualisierenden Lerneinheiten gemeinsam, was nicht nur die Qualität erhöht, sondern auch eine arbeitsteilige Entlastung bringt. Neue Lehrpersonen werden durch erfahrene Kolleginnen und Kollegen begleitet und erhalten eine strukturierte Einführung in das neue Konzept. Mit diesem neuen Unterrichtsmodell geht wir an der NMS einen Schritt hin zu einer modernen und zukunftsfähigen Lernkultur, in der Schülerinnen und Schüler gezielt auf die Anforderungen einer dynamischen Welt vorbereitet werden.
Reise des Schwerpunktfachs Musik nach Wien: Viele Museen, Konzerte und ein eigener Videoclipdreh
Die Schwerpunktfach-Musik-Klasse des Jahrgangs GYM4 verbrachte im Januar 2025 ihre Sonderwoche in Wien, wo sie viele grossartige Konzerte und Opern besuchte. Die Reise verbanden die Lernenden mit der Realisierung eines eigenen Videoclips zum Song «Road of Dreams», den einer der Schüler, Yorin Moll, selbst geschrieben hat. In dem Song geht es darum aufzubrechen und neue Wege im Leben zu gehen. Die fremde Grossstadt Wien brachte hierfür viele passende Drehorte mit wie der Stephansplatz, der Stadtpark oder verschiedene U-Bahnstationen. Die Drehtage verschoben sich jeweils in die Nacht, da wir tagsüber Museen besuchten und abends immer in einem Konzert waren. Ein Vorteil der Nacht-Drehs war, dass nach 01.00 Uhr die U-Bahn, der Stadtpark und viele Strassen Wiens menschenleer waren und sich die Szenen somit beliebig wiederholen liessen, ohne dass man jemanden störte.
Diese erlebnisreichen Tage in Wien und weitere Drehtage in Bern mündeten in einem Videoclip, den man auf unserem NMS-Youtube-Kanal anschauen kann: -

Zeitgenössische Kunst in direkter Nachbarschaft der NMS
Direkt gegenüber der NMS liegt die Stadtgalerie – ein idealer Lern- und Forschungsort für zeitgenössische Kunst. Doch gerade diese Art von Kunst fordert uns oft heraus, sie zu ergründen und neue Perspektiven zuzulassen. Mit verschiedenen kreativen Techniken haben sich die Schülerinnen des Schwerpunktfachs Bildnerisches Gestalten GYM2 und GYM3 behutsam an die Werke von Rhoda Davids Abel und Sergio Rojas Chaves herangetastet.
Dabei haben sie nicht nur Fragen gestellt, sondern sich auch in die Thematik der Ausstellung vertieft. Der Titel der Ausstellung, Super Bloom, ist dabei ein faszinierender Begriff: Zur Superblüte entfaltet sich eine aussergewöhnlich hohe Anzahl von Wildblumen gleichzeitig. Doch wie lässt sich diese Information mit dem, was wir in den Kunstwerken sehen, in Verbindung bringen? Welche Beziehung haben die ausgestellten Werke zu unserem eigenen Leben? Was assoziieren wir mit dem Begriff „Exotik“? Und welche Rolle spielen unsere Zimmerpflanzen in diesem Kontext?
Um diese Fragen zu beantworten, war kognitive Kreativität gefragt! Am Ende hatten wir die Gelegenheit, uns mit der Leiterin der Stadtgalerie und Kuratorin der Ausstellung auszutauschen. Sie erzählte uns von ihrem beruflichen Werdegang und nahm sich Zeit, unsere Eindrücke zur Ausstellung aufzunehmen.